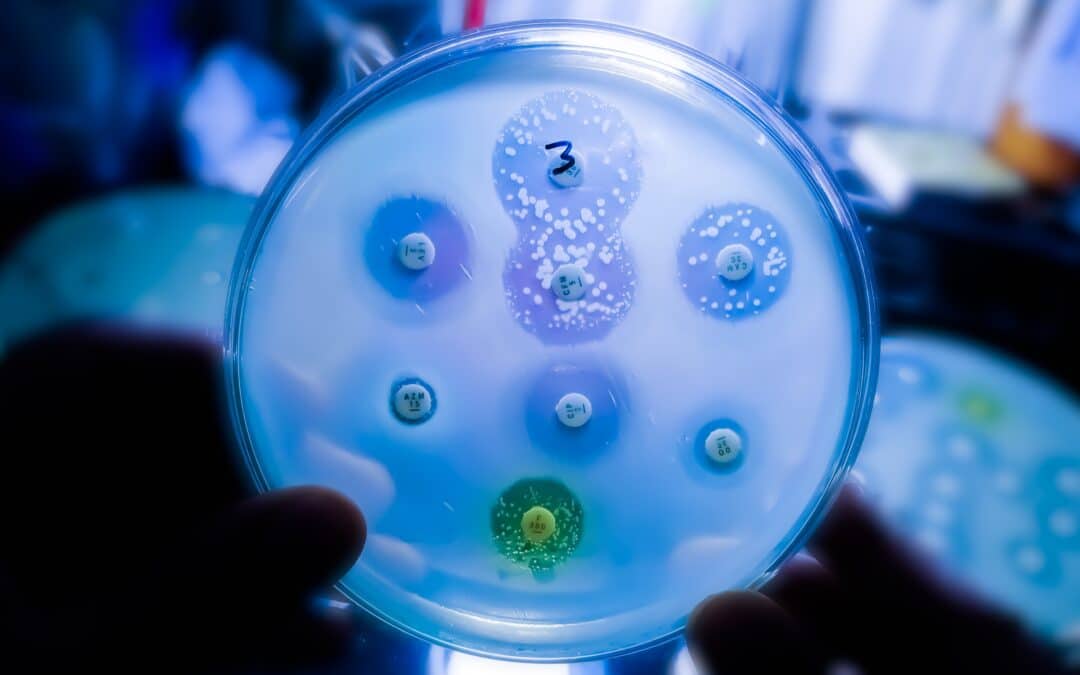
Tackling the antimicrobial research and development and access crisis: an overview

by European Public Health Alliance | Aug 6, 2024 | Opinion
Guest Article by Alejandro Tlaie, Ernst Strüngmann Institute for Neuroscience, and Jaisalmer de Frutos Lucas, European Public Health Alliance. Large Language Models (LLMs) are advanced AI systems designed to understand and generate human-like text based on the data...

by European Public Health Alliance | Jul 19, 2024 | Opinion
Guest Article by Erik Ruiz, Healthcare without Harm Our recommended targets for the UNGA High Level Meeting on AMR According to current data AMR causes 1.27 million deaths every year. If no further action is taken in the right direction, by 2050 it could cause as...

by European Public Health Alliance | Jul 19, 2024 | Opinion
Guest Article by David McKinney, the Alliance for reducing Microbial Resistance ARMoR The importance of antimicrobial medicines in the modern world cannot be overstated, with some studies estimating they have increased average human life expectancy by up to 23 years....

by European Public Health Alliance | Jun 24, 2024 | Opinion
The World Health Organisation (WHO) Europe has published its report on the Commercial Determinants of Non-Communicable Diseases (CDoNCD) in the European Region. The report builds on the Lancet series on the Commercial Determinants of Health, and it explores how...

by European Public Health Alliance | Jun 20, 2024 | Opinion
Guest Article by EU Food Policy Coalition The EU Food Policy Coalition (EU FPC) brings together NGOs from a broad spectrum working on food systems, including grassroots social movements, farmers organisations, organisations of fishers, trade unions, think tanks,...

by European Public Health Alliance | Jun 19, 2024 | Opinion
Guest Article by Beatrice Credi, Head of Brussels Office, European Liver Patients’ Association (ELPA) Linking Liver Health to Public Health Liver health is intrinsically linked to the overall public health landscape. Chronic liver diseases, such as hepatitis, fatty...